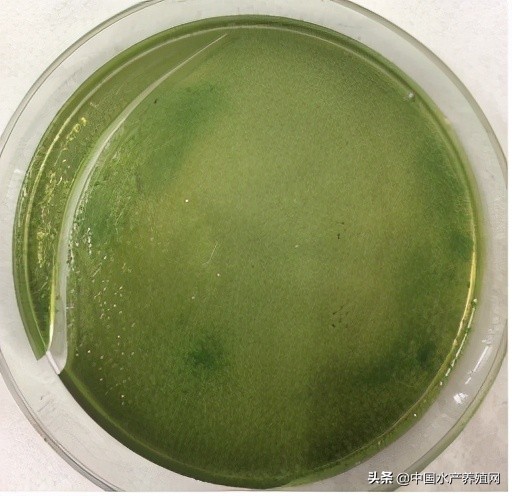
中草药制剂HCV弧菌病能防治、修复肝胰腺，广东省农业力推技术

弧菌病困扰对虾养殖已久。防不住,治不好是养虾人的无奈。弧菌病引发的肝胰腺萎缩、白便、偷死等病症更是让养虾人提心吊胆。拨开纷杂的病症,主推技术从病根弧菌病入手,诠释能治能防能修复肝胰腺。
二、主推技术中草药复方制剂HCV治疗弧菌病,效果100%
本技术从2017年开始虾塘试验,基本上都是治疗对虾弧菌病,至今至少服务50000个塘次,有效率100%。以下仅介绍新会区农业部门组织大鳌镇和睦州镇农办等一起验证的案例和详细记录。
2018年3月12日下午,新会区大鳌镇四村陈老板告知普精技术员,发现塘底有偷死约10斤,前一天下午1点按平常喂料40斤到下午5点还没吃完。陈老板在虾塘表现得很无奈,不知如何是好。
朱盛山教授与新会区农业局余股长和大鳌农办梁主任、黄主任和睦州镇农办周主任,以及来自广西北海、湛江、汕头的技术人员,一行十几人来到塘边。观察发现虾活力不够,虾体不够通透,有空肠空胃、断肠的现象,肝胰脏萎缩,粪便长条,还有白便、偷死较多。
1、虾塘观察与咨询
|
实验地点 |
大鳌四村 |
平均体重/g |
6.8/只 |
虾规格(cm) |
5-7 |
|
虾塘面积(亩) |
11 |
养殖阶段(天) |
61 |
投苗数(万尾) |
40 |
|
病前吃料(斤)/餐 |
50斤、2h |
病虾吃料量(斤) |
40斤、4h(未吃完) |
治疗后吃料量(斤) |
45斤、2h |
2、病虾症状与诊断
病虾活动能力弱,食欲减退,慢料、减料,虾身瘦弱,体色偏黑,有肌肉白浊,断肠、空肠,肝胰腺萎缩、糜烂、白膜消失,拖便、浮便、白便、偷死等。
诊断 :弧菌病。
3.体内抑杀弧菌实验
比较病虾吃中草药复方制剂HCV前和一小时后,肝胰腺、肠道弧菌TCBS培养情况。
3.1对照组:用药前取发病虾塘吃料虾3条。用清水洗净虾体后、剖取虾肝胰腺和肠道,用清水洗净,加2ml水自来水,捣碎,吸取3滴于TCBS 培养皿中,用涂布棒均匀涂抹,做好标记,放置在室温度,培养24小时后,观察并记录肝胰腺和肠道弧菌量。
3.2给药组:喂中草药复方制剂HCV拌料1小时后,于料台抓吃料虾三条,用清水洗净,剖取虾肝胰腺和肠道,用清水洗净,加2ml水自来水,捣碎,吸取3滴于TCBS 培养皿中,用涂布棒均匀涂抹,做好标记,放置在室温度,培养24小时后,观察并记录肝胰腺和肠道弧菌量。
虾体内肝胰腺、肠道弧菌培养结果表
|
组别 |
结果(CFU/ml) |
|
中草药复方制剂HCV组 |
0 |
|
对照组 |
>108 |
3.3 结果 24h培养结果见图
用药前肝胰腺和肠道

用药后肝胰腺和肠道
4. 效果全记录(详见附件)
4.1用药方案: 一个疗程用药两次,第一天下午和第二天早上各一次。每次用药量按中草药复方制剂HCV标示量制定(见下表),按标示量取中草药复方制剂HCVⅠ、Ⅱ号,混匀。加中草药复方制剂HCV的8倍量饲料,拌匀,晾10分钟,投喂。用药两次,第一次,在2018年3月13号下午用药;第二次在3月14号上午用药。
|
第一次 |
15:30 |
拌料量(g) |
16斤 |
第二次 |
7:30 |
拌料量(g) |
16斤 |
|
1号(g) |
200 |
2号(ml) |
1000 |
1号(g) |
200 |
2号(ml) |
1000 |
4.2用药结果
记录见下表
|
观察指标 |
用药前 D0 |
用药后 |
||
|
D1 |
D2 |
D3 |
||
|
行为(活力) |
活力下降 |
增强 |
增强 |
增强 |
|
体色 |
发暗 |
逐渐通透 |
正常 |
正常 |
|
躯壳 |
虾身瘦弱 |
减少 |
正常 |
减少 |
|
须 |
断须 |
减少 |
正常 |
减少 |
|
眼球 |
突出 |
减少 |
无 |
无 |
|
肝胰腺 |
萎缩 |
减少 |
正常 |
正常 |
|
肠道 |
断肠、空肠 |
减少 |
正常 |
正常 |
|
腿部 |
黄腿 |
减少 |
减少 |
减少 |
|
尾扇 |
发红 |
减少 |
正常 |
正常 |
|
肝胰脏(颜色、界线、白膜) |
无血色、界线不分明、白膜不完整 |
有血色、界线分明 |
有血色、界线分明 |
有血色、白膜清晰 |
|
肠道 |
细瘦、不饱满 |
饱满 |
饱满 |
饱满 |
|
肌肉 |
白浊 |
减轻 |
正常 |
消失 |
|
肠道、肝胰脏TCBS涂板 |
超标 |
感 43 肠 23 |
无 |
无 |
|
游塘(趴边)量 |
无 |
无 |
无 |
无 |
|
白便量 |
很多 |
减少 |
减少 |
减少 |
|
偷死量 |
10斤 |
5斤 |
4斤 |
2斤 |
|
粪便长度 |
大于4cm、拖便 |
小于4cm |
无拖便 |
无拖便 |
|
吃料多少 |
40斤/餐、4h |
35斤/餐、3h |
40斤/餐、2.5h |
45斤/餐、2h |
4.3用药前虾症状图
症状简述: 病虾活动能力减弱,虾身瘦弱,体色偏黑,断肠、空肠,肝胰腺萎缩、糜烂、白膜消失,拖便、浮便、食欲减退,慢料、减料,白便、偷死。
3.1体表


3.2解剖


3.3粪便长度

3.4偷死:


4.4用药后虾症状图
4.4.1一次用药效果: 虾的活力明显增强,料台拖便基本没有,白便减少,空肠空胃、断肠的虾由原来三层减少到一层,肝脏白膜比较完整,虾体色通透,偷死减少,吃料加快。
(1)体表


(2)解剖


(3)粪便长度

4.4.2二次用药效果 虾的活力正常,料台白便、拖便基本没有,空肠空胃、断肠的虾偶尔见到一、二条,偷死减少,肝脏白膜清晰,肝脏有血色,虾体色通透,吃料恢复正常。
(1)体表


(2)解剖

(3)粪便的长度

结论:中草药复方制剂HCV防治弧菌病效果经得起验证,比抗生素更好。
附件1 中药中草药复方制剂HCV对虾康复方案

附件2 中草药复方制剂HCV治疗弧菌病临床实验记录表


验证实验成员合影

一、主推技术全程预防,小投入,高回报
养殖户肯定了治疗效果后,开始有人试着做预防。对虾发病了,即使能治好,还是或多或少减少收成,防比治更重要。近二年来,试着用中草药复方制剂HCV预防的养殖户越来越多。以下介绍*江阳**2020年6月一例:
*江阳**陈老板,高位池12个养虾,11个采用中草药复方制剂HCV进行全程预防,每个池1-1.2亩,每亩放苗30万尾。

1、2020年6月30日放苗,每个池投苗约30万尾,每袋虾苗约4000尾,投苗前,将中草药复方制剂HCVⅢ号注入虾苗袋1毫升,浸泡5~10 min,解袋放苗。消除应激反应,提高成活率。
2、养殖 全程预防池11个,一出现慢料,第二餐就使用中草药复方制剂HCV,另外,台风来临用一次,用中草药复方制剂HCV见下表。对照池1个。用中草药复方制剂HCV预防依据标示用法用量计算,以一个池(03号)为例,见下表。
|
中草药复方制剂HCVI号(克) |
中草药复方制剂HCVII号(毫升) |
饲料(克) |
|
|
06 30 |
20 |
100 |
600 |
|
0705 |
30 |
150 |
800 |
|
0717(转肝) |
50 |
250 |
2000 |
|
0718(转肝) |
50 |
250 |
2000 |
|
0729 |
50 |
250 |
2000 |
|
0803 |
100 |
500 |
3000 |
|
0809 |
100 |
500 |
3000 |
|
0816 |
100 |
500 |
3000 |
|
0820 |
100 |
500 |
3000 |
|
0821 |
100 |
500 |
3000 |
|
0823(台风) |
100 |
500 |
3500 |
|
0831 |
100 |
500 |
3500 |
|
0904(台风) |
150 |
750 |
5000 |
|
0911(收虾前) |
150 |
750 |
5000 |
|
用中草药复方制剂HCV12套,4416元,收虾6650斤,卖12.50万元。 |
|||
所有预防塘(11个),用中草药复方制剂HCV共130套,4.7850万元。 9月15-16日,先后收虾7.55万斤,18/斤,卖136万元。
对照池1个未用中草药复方制剂HCV采用其常用的消毒、改底等和投喂抗生素,养殖32天,排塘。
很容易看出,用本技术中草药复方制剂HCV预防对虾弧菌病效果是肯定的,是小投入,高回报。
三、主推技术中草药复方制剂HCV保护、修复对虾肝胰腺
修复对虾受损的肝胰腺亦是弧菌病防治工作关键。下图为使用中草药复方制剂HCV一次后,对虾肝胰腺中溶菌酶、酸性磷酸酶、碱性磷酸酶、谷草转氨酶的活性变化。可见,使用中草药复方制剂HCV一次后,对虾肝胰腺酶活性显著增强,对虾免疫力提升,修复和保护肝胰腺。


注:上一组图是实验研究结果,下一组是大塘试验结果。
从症状表现看下图(大塘试验结果)使用中草药复方制剂HCV一次后,对虾肝胰腺萎缩、炎症逐渐消失,轮廓变得饱满、清晰,白膜覆盖率提升,且白膜的清晰度提高。



使用中草药复方制剂HCV一次后,肝胰腺症状逐步恢复,轮廓逐步饱满、清晰,白膜逐步覆盖完整
主推技术中草药(中草药复方制剂HCV)能防能治对虾弧菌病,还能修复、保护对虾肝胰腺。
朱教授团队随时随地欢迎养殖朋友试验和验证,欢迎朋友加盟合作推广本技术,让更多养虾人不再害怕弧菌病。